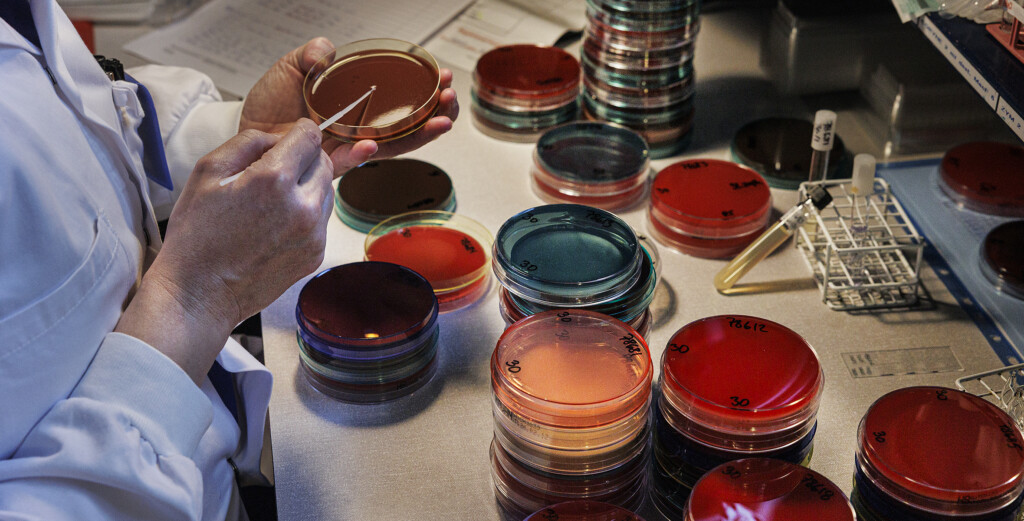
Person stryker bakterier på agarplatta.

Mat & jordbruk
Okända infektioner identifieras i Sveriges största bakteriebank

I en källarlokal i Göteborg finns en av världens viktigaste bakteriesamlingar. I snart 60 år har materialet isolerats och sparats, bland annat från patienter med ovanliga infektionssjukdomar. Kan bakterierna bidra med viktiga nycklar för att lösa problemet med antibiotikaresistens?
Prenumerera på Extrakts nyhetsbrev!
Läs mer
Håll dig uppdaterad! Få kunskapen, idéerna och de nya lösningarna för ett hållbart samhälle.
Personuppgifter lagras endast för utskick av Extrakts nyhetsbrev och information kopplat till Extrakts verksamhet. Du kan när som helst säga upp nyhetsbrevet, vilket innebär att du inte längre kommer att få några utskick från oss
Det doftar jordgubb, med inslag av smultron. Den biomedicinska analytikern Susanne Jensie Markopoulos har arbetat så länge att hon kan identifiera distinkta dofter, inte helt olikt en sommelier. Men i stället för ett exklusivt vin sitter hon lutad över en bakterie.
– Ibland fungerar näsan bra för preliminär artbestämning, men de flesta bakterier luktar ingenting. Om de luktar så är det oftast lite unket, som när man öppnar kylskåpet och känner att något blivit dåligt. Sedan finns det vissa som doftar riktigt gott, som den här. Jag är säker på att det är Pseudomonas aeruginosa, säger Susanne Jensie Markopoulos.
Bakterien i fråga må dofta gott, men är en ganska otrevlig rackare. Den trivs i variga sår och i slem. Patienter med cystisk fibros kan ha bakterien i sina lungor.
Europas största bakteriesamling
De allra flesta ryggar nog tillbaka lite vid tanken på bakterier. Susanne Jensie Markopoulos gör tvärtom. Efter att ha jobbat i 24 år har hon sett det mesta. Snart uppmanar hon oss att lukta igen.
– Den här luktar champinjon och svampskog. Ibland kan den lukta lite våt hund. Det är en Neisseria, som exempelvis kan finnas i svalg. Även hos hundar faktiskt, säger Susanne Jensie Markopoulos.
I en anspråkslös källarlokal på Sahlgrenska universitetssjukhuset i Göteborg ligger CCUG, Culture Collection University of Gothenburg. Det är Europas största bakteriesamling.
Många av bakterierna här är unika, och säljs bland annat till forskare, sjukhus och företag för vaccinutveckling, kvalitetskontroller och forskning.

Används för att utveckla vacciner
Vid det här laget innehåller bakteriesamlingen nästan 80 000 bakterier. Liselott Svensson är mikrobiolog och biträdande föreståndare för CCUG. Hon vill visa oss något.
– Nu går vi in till det heligaste, till guldgruvan! Det här är vårt kylrum där vi förvarar alla glasampuller med frystorkade bakterier, säger Liselott Svensson.
Det är kylskåpskallt och det lilla rummet vi kliver in i hade kunnat vara som vilken lagerlokal som helst. Pulvret i botten på varje ampull ser inte heller mycket ut för världen. Det är lite grådaskigt i färgen, men har potential att göra stor nytta.
– Om forskare eller sjukhus behöver bakteriestammar för att utveckla ett nytt vaccin kan de vända sig hit, säger Liselott Svensson.
Allt fler bakterier är antibiotikaresistenta
Att bakteriesamlingen är Europas största är mycket tack vare mikrobiologen Enevold Falsen.
Länge var det hans jobb att artbestämma svåridentifierade bakterier från Sahlgrenska universitetssjukhusets patientprover. Om en person drabbas av en ovanlig infektionssjukdom måste bakteriestammen identifieras för att läkaren ska kunna sätta in rätt behandling. När rutinlabbens mikrobiologer inte kände igen bakterierna skickades de ner till Enevold Falsen. Med åren utvecklade han metoderna för identifiering. Han bestämde sig också för att spara alla isolat – de bakterier som han odlat fram ur patientprover. Det var så CCUG grundades 1968.
– Det är vi tacksamma för i dag. Vi är störst i världen när det gäller just kliniska isolat, säger Liselott Svensson.
På senare år har Sahlgrenskas rutinlabb blivit så bra att CCUG inte får lika många prover från sjukhuset längre. Men hit skickas också helt andra bakterier för identifiering. Det kan till exempel röra sig om ett kosmetikabolag som tillverkar krämer eller ett livsmedelsföretag som behöver hjälp att artbestämma bakterier som de har hittat på en arbetsbänk.
Bakterierna odlas upp på agarplattor, runda plastbehållare med olika substrat som olika bakterier gillar att växa på. För säkerhets skull görs oftast en gensekvensering också som ett led i idenfieringen. Allt som är tillräckligt ovanligt frystorkas och sparas.
Allt fler bakterier de fått in på senare tid är antibiotikaresistenta, vilket också är föremål för forskning.



En livförsäkring
Högst upp i huset ligger avdelningen för infektionssjukdomar, som bland annat arbetar för att motverka problemet med antibiotikaresistens. Daniel Jaen Luchoro är forskare och nybliven kurator för CCUG. Det betyder att han är föreståndare för bakteriesamlingen.
Antibiotikaresistens kallas ibland för den tysta pandemin. Redan nu dör uppskattningsvis 700 000 personer per år som en direkt följd av antibiotikaresistens.
– Antibiotika används för att behandla infektioner som orsakas av bakterier. Problemet med antibiotikaresistens är att en infektion som vi enkelt kan behandla i dag kan bli livshotande om 20 år om antibiotikan inte fungerar. Man behöver leta efter alternativa mediciner eller behandlingsmetoder, säger Daniel Jaen Luchoro.
Han konstaterar att det finns gott om resistenta bakterier, även bland de som skickas till CCUG. I många fall har man identifierat mekanismerna bakom resistensen, men inte alltid. I sin egen forskning jobbar han därför med ett projekt som söker nya angreppsmål mot antibiotikaresistens och bland annat gör analyser med hjälp av artificiell intelligens.
– Man kan tänka på bakteriesamlingen som en livförsäkring och en resurs som alla forskare kan ha nytta av. Vi vet inte vilka problem vi kommer att stöta på i framtiden, och då behöver vi vara förberedda, säger Daniel Jaen Luchoro.



Skördar bakterier
Tillbaka i källaren är den biomedicinska analytikern Susanne Jensie Markopoulos i full färd med att skörda artbestämda bakterier. De ska lagras in i kylrummet och sparas för eftervärlden.
Susanne Jensie Markopoulos blandar ihop en speciell frystorkningsbuljong som hon sprider ut över agarplattan. Försiktigt skrapar hon upp innehållet från plattan med en rackla, en böjd stav i platinum, innan det försiktigt hälls ner i ett glasrör. För att undvika kontaminering bränner hon rent racklan med en gasollåga. Först när hon är klar tittar hon upp från arbetsbänken.
– Jag känner mig nästan som en glaskonstnär när jag gör det här. Men jag vill inte prata när jag håller på för det finns alltid en risk att jag får in föroreningar då, och proverna måste vara helt rena. Just det här får nummer 78 618 och det är eventuellt en helt ny art. Visst är det spännande? Jag tröttnar aldrig, säger Susanne Jensie Markopoulos.








